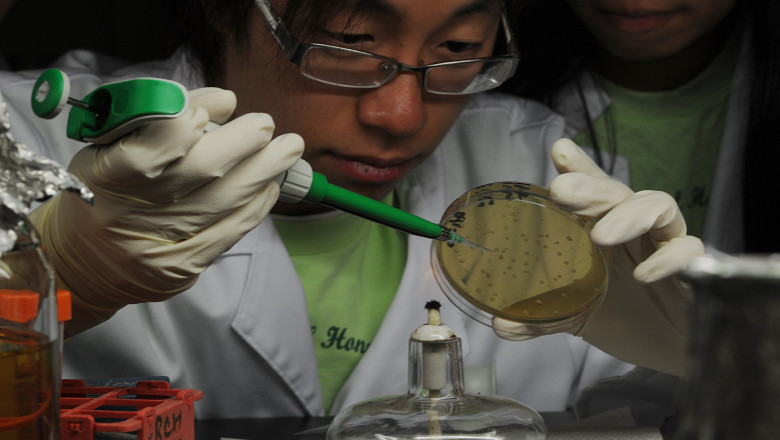
Utilitar. Reguli pentru donarea de celule stem Imagine

Mai întâi contactaţi Registrul de celule stem. Veţi fi îndrumat către Centrul Donatorilor, unde vă veţi da consimţământul şi veţi completa un chestionar medical. Vi se recoltează sânge pentru analize şi, dacă rezultatele sunt bune, veţi fi anunţat printr-o scrisoare că aţi devenit donator.
Caracteristicile dumneavoastră genetice vor fi comparate cu ale celor care au nevoie de transplant. Când sunteţi identificat ca fiind compatibil cu un pacient, veţi fi chemat pentru analize suplimentare. Urmaţi apoi procedura de recoltare a celulelor stem.